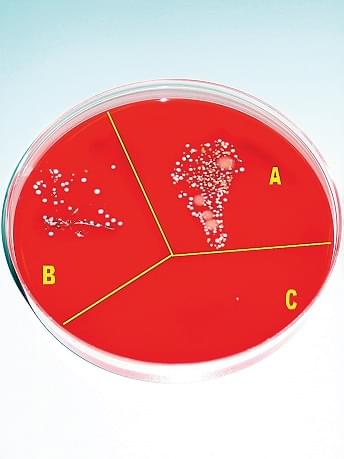

Главной медицинской проблемой современности считаются сердечно-сосудистые и онкологические заболевания. А в XVII–XIX веках лучшие умы боролись с «родильной горячкой». По всей Европе огромное число рожениц умирало от сепсиса после родов. За первые 60 лет XIX века в Пруссии так погибло 363 624 женщины – больше, чем от оспы и холеры. В некоторых родильных домах смертность достигала 30–50 %, а хорошим показателем считались 10 %. Удивительным было то, что в результате домашних родов (и даже случайных, на улице или в поле) женщины умирали гораздо реже. В больницы шли только те несчастные, кто не мог оплатить услуги повитух.
Почему же под присмотром профессиональных акушеров смертность была выше, чем у необразованных повивальных бабок? Никто не мог этого понять. Профессора медицины предлагали разные версии: возможно, заражение исходит от плохой почвы или погоды и распространяется только в определенных местах, а возможно, имеет эпидемический характер. Устоявшимся объяснением горячки была «атмосферно-космическая» теория, согласно которой болезнь порождают вредоносные свойства кислорода и витающие в больничном воздухе «миазмы». Надышавшиеся ими роженицы якобы не справлялись с заразой. Горячку пытались побороть десятками методов – от проветриваний до приема слабительного, но в конце концов признали непобедимой.
МОЛОДОЙ ВЕНГР Игнац Филипп Земмельвайс специально выучился на врача-акушера, чтобы найти лечение послеродового сепсиса. В 29 лет он стал ординатором крупнейшей венской больницы. Лучше места для его задачи было не найти: в клинике размещалось 2 тыс. коек и ежегодно рожали до 6 тыс. женщин. К тому же там велась статистика – к ней и обратился Земмельвайс. Первой странностью, которую он заметил, был разный процент выживших после родов в двух отделениях. Но не могут же миазмы «симпатизировать» одному отделению больше, чем соседнему! А единственная разница между ними была в том, что в отделении с низкой смертностью трудились в основном повитухи, а в другом – студенты и врачи, которые много работали в анатомическим театре и препарировали трупы. Смертность возросла в разы именно тогда, когда в клинике ввели патологоанатомические занятия для студентов, которые и принимали роды, и осматривали пациенток.
 Центральный клинический госпиталь Вены, 1784 г.
Центральный клинический госпиталь Вены, 1784 г.
Окончательно к открытию причин заражения Земмельвайса привело одно событие. Умер его друг, доктор судебной медицины Якуб Колетшка. И не просто умер – он заболел, порезавшись во время вскрытия очередной роженицы. Земмельвайс говорил потом: «Заболевание и смерть Колетшки были вызваны трупными веществами, занесенными в кровеносные сосуды… а разве не может быть, что женщины, погибшие от этой же болезни, заболевали именно при попадании трупных веществ в сосуды? Ответ напрашивался сам собой; разумеется, да, ибо профессора, ассистенты и студенты немало времени проводили в морге за вскрытием трупов, и трупный запах, очень долго сохраняющийся на руках, свидетельствует о том, что обычное мытье рук водой с мылом еще не удаляет всех трупных частичек…»
Сегодня то, что происходило с роженицами в больницах, называется эндометрит с септическим осложнением (воспаление слизистой оболочки матки). Чтобы его избежать, необходимо предотвратить загрязнение рук и инструментов врачей.
Дело в том, что врачи прямо из морга шли принимать роды и таким образом заражали пациенток. Они не всегда мыли руки хотя бы водой. Один ученик Земмельвайса признался, что, будучи вызванными из морга, «студенты переходят улицы, вытирая руки, еще влажные от крови, носовыми платками, и прямо идут обследовать рожениц…». Так Земмельвайс понял, что горячка – это частный случай раневого сепсиса.
ПОСКОЛЬКУ ДАЖЕ МЫЛО не удаляло с рук трупный запах, Земмельвайс решил применить для обеззараживания раствор хлорной извести и запретить препарировать трупы за 1–2 дня до осмотра женщин. С большим трудом он уговорил директора клиники, профессора Иоганна Клейна, провести эксперимент. И однажды при входе в родильное отделение появилось объявление: «Начиная с сего дня, 15 мая 1847 года, всякий врач или студент, направляющийся из морга в родильное отделение, обязан при входе вымыть руки в находящемся у двери тазике с хлорной водой. Строго обязательно для всех без исключения. И. Ф. Земмельвайс». Это был прорыв: в том же году смертность в больнице снизилась до 5 % (вместо 11 % в предшествующем), а в 1848 году – до 1,3 %. С того момента и до сих пор хлоркой пользуются в целях дезинфекции.
ИГНАЦ ЗЕММЕЛЬВАЙС был вовсе не первым, кто задумался о важности чистоты при медицинских манипуляциях. За много веков до него целители использовали в качестве антисептика травы, соль, алкоголь, керосин и т. д., а знаменитые хирурги практиковали свои способы избежать гнойных осложнений после ранений и операций. Но серьезные исследования в этой области начались только в середине XIX века.
Земмельвайс добился поразительного результата всего через полгода. В одной только клинике Клейна он спас от смерти тысячи рожениц! Будущие матери употребляли все хитрости, чтобы попасть именно в его отделение. Такое открытие обещало молодому доктору громкую славу и благодарность миллионов. Но неожиданно началась травля. Ни директор клиники, ни другие именитые акушеры не признали его достижение. Профессор Клейн запретил публикацию результатов нововведения и заявил, что «посчитает такую публикацию доносом». Он использовал свой авторитет, чтобы правительство не создало комиссию для проверки и апробации методики Земмельвайса. Ведь Земмельвайс не только бил по репутации врачебного сообщества, но еще и насмехался над Клейном за его веру в «атмосферно-космическую» теорию, и требовал, чтобы директор тоже мыл руки в тазике с хлоркой.
Австрийский врач Фердинанд Риттер фон Гебра – основоположник дерматологии; создал первую классификацию кожных заболеваний и ряд методов их лечения, открыл причины чесотки (чесоточный клещ) и изобрел водный матрац для профилактики пролежней.

ИГНАЦ НАЧАЛ ОТПРАВЛЯТЬ частные письма коллегам с предложениями опробовать его методику, но лишь некоторые сделали это открыто, в том числе его друг Фердинанд фон Гебра. Еще один врач, Густав Михаэлис, доверился Земмельвайсу… и покончил с собой от потрясения, когда смертность в его клинике резко упала. А остальные игнорировали Земмельвайса. И когда срок его ординатуры подошел к концу, Клейн не продлил контракт и приказал прекратить «хлорные опыты» в учреждении.
ТОГДА ЗЕММЕЛЬВАЙС, которому с трудом удалось найти место в будапештской больнице св. Рохуса для нищих, стал открыто обвинять врачей в убийственной практике и твердолобости. Враги называли это «спекулятивным буйством». Он писал статьи, выступал на конференциях и даже на свои деньги организовал семинар по обучению дезинфекции. Но никто не пришел туда! Немногие последователи опасались насмешек и скрывали, что пользуются хлоркой. Друзья помогли Земмельвайсу издать в 1861 году монографию «Этиология, сущность и профилактика родильной горячки» (Die Aetiologie, der Begriff und die Prophylaxis des Kindbettfiebers). Но снова автор не получил ничего, кроме злобной критики. Пытаясь выставить Земмельвайса шарлатаном, в больницах подделывали статистику смертности от родильной горячки (например, переводили заболевших женщин из родильного в другие отделения). Больше всех негодовали в Пражской акушерской клинике, где врачи особенно не хотели признавать свою вину в трагедиях. От сепсиса там умирали слишком многие: в 1848 году – 37 % рожениц, в 1849-м – 45,5, в 1850 году – 52,6 %. Никто не хотел соглашаться с тем, что он убийца.
 Друзья помогли Земмельвайсу издать в 1861 г. монографию «Этиология, сущность и профилактика родильной горячки», www.thefullwiki.org
Друзья помогли Земмельвайсу издать в 1861 г. монографию «Этиология, сущность и профилактика родильной горячки», www.thefullwiki.org
После многих лет борьбы и унижений Земмельвайс впал в глубокую депрессию. Порой он даже не мог вести связный разговор. Видя все это, Фердинанд фон Гебра пригласил его с женой в новый санаторий в Дёблинге. «Санаторий» оказался психиатрической лечебницей, а лечащий врач заявил о необходимости госпитализировать Земмельвайса. Тот наотрез отказался и, пытаясь убежать, подрался с санитарами. Его избили, замотали в смирительную рубашку и бросили в карцер, прописав обливания холодной водой. Спустя две недели Земмельвайса не стало – в возрасте 47 лет. По иронии судьбы, причиной его смерти оказалась не жестокость «лечения», а сепсис. Как когда-то Колетшка, Земмельвайс незадолго до поездки порезался во время операции.
ВСЕГО ЧЕРЕЗ НЕСКОЛЬКО ЛЕТ врачебное сообщество вынуждено было признать правоту Земмельвайса. А то, что с ним случилось, получило название «рефлекса Земмельвайса»: психологически обусловленный отказ от проверки новых научных данных, если они противоречат устоявшейся теории. Нередко жертвой этого рефлекса становятся именно молодые ученые, которым накопленный опыт не мешает выдвигать смелые гипотезы, но которые еще не имеют авторитета, достаточного для защиты своих открытий.
Еще один известный случай «рефлекса Земмельвайса» произошел с немецким метеорологом Альфредом Вегенером, открывшим в 1912 году континентальный дрейф. Он первый смог убедительно объяснить схожесть очертаний береговых линий Африки и Южной Америки, их флоры и фауны. Около 200 млн лет назад континенты откололись от огромного материка, который Вегенер назвал Пангея, и с тех пор «плывут» по поверхности планеты. Десятилетиями эту теорию называли «архаичной» и «серьезным заблуждением», а одним из острых критиков был свекор самого Вегенера (тоже метеоролог). Находя и критикуя мелкие недостатки теории континентального дрейфа, геологи отвергали заодно и ее суть. Это продолжалось до 1960-х годов, пока не накопилось настолько много неопровержимых доказательств правоты Вегенера, что отрицать теорию стало невозможно (подробнее о судьбе Вегенера читайте в январском номере «ММ» за 2016 год. – Ред.).
НЕЛЬЗЯ НЕ ПРИЗНАТЬ, что, помимо психологических причин, к неудаче Земмельвайса привело и отсутствие убедительной теоретической базы. Для многих его блестящее открытие выглядело как догадка, дикая и ненаучная. Ни Земмельвайс, ни кто-либо другой еще не знали тогда о бактериальной природе сепсиса. В применении хлорки для снижения заболеваемости горячкой видели не больше связи, чем в предложении носить красные колпаки для борьбы с ветрянкой.
Подлинное признание Земмельвайса пришло благодаря британскому хирургу Джозефу Листеру. В 1864 году он решил освежить больничный воздух от «миазмов», обработав стены и хирургические инструменты фенолом (карболкой), который использовался тогда для улучшения запаха сточных вод. Идея была проста: если ядовитый фенол освежает воду, то и воздух освежит. И это сработало, смертность от сепсиса снизилась. Над Листером тоже стали посмеиваться, но ему повезло: спустя год Луи Пастер доказал, что гниение вызывается болезнетворными бактериями, а не возникает само по себе «из воздушных миазмов». Открытие Пастера позволило Листеру теоретически обосновать свой опыт. Стало понятно, что карболка уничтожала микробы на поверхности предметов и кожи. Хирург начал обрабатывать ею все, даже пытался с помощью пульверизатора насытить раствором фенола воздух в операционной (пришлось от этого отказаться из-за жжения в глазах). В 1867 году Листер опубликовал статью «Об антисептических принципах в хирургической практике». Постепенно ему удалось завоевать признание коллег, и тогда открытие Земмельвайса стало видеться в другом свете.

Микробные культуры, демонстрирующие эффективность дезинфекции: без дезинфекционных процедур (А), после мытья рук с мысло (В) и после дезинфекции спиртом (С), www.thefullwiki.org
Вскоре антисептические методы начали применять повсеместно, и родильная горячка, которая свирепствовала в больницах более двухсот лет, была побеждена. Вся хирургия встала на новый уровень. Переломы, травмы, операции, прежде почти не оставлявшие пациентам шансов на выживание, стали рядовыми и практически не опасными. И так поздно признание пришло к тому, кто нашел спасительное средство. С 1906 года в Будапеште, родном городе Земмельвайса, стоит памятник его героической борьбе за жизни рожениц, на котором написано: «Спасителю матерей».


 В отделении с низкой смертностью работали в основном повитухи. www.gettyimages.com
В отделении с низкой смертностью работали в основном повитухи. www.gettyimages.com
 Будапештский медицинский университет, www.semmelweis.hu
Будапештский медицинский университет, www.semmelweis.hu
 Друзья помогли Земмельвайсу издать в 1861 г. монографию «Этиология, сущность и профилактика родильной горячки», www.thefullwiki.org
Друзья помогли Земмельвайсу издать в 1861 г. монографию «Этиология, сущность и профилактика родильной горячки», www.thefullwiki.org

Разложение по полочкам
Разложение по полочкам Баланс ценностей
Баланс ценностей Выследить и вынюхать. Трасология и одорология в криминалистике
Выследить и вынюхать. Трасология и одорология в криминалистике Никакого наркоза
Никакого наркоза 








